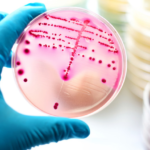

Në një zbulim të madh shkencor, astronomët kanë zbuluar një planet të ri të ngjashëm me karamelet flokë-sheqer shumë jashtë sistemit tonë diellor, raportoi Space.
Eksoplaneti i quajtur “WASP-193 b” është rreth 1.5 herë sa gjerësia e Jupiterit, megjithatë ai përmban vetëm një pjesë të densitetit të tij.
Shkencëtarët kanë zbuluar se planeti gjigant me gaz është planeti i dytë më i lehtë i zbuluar në kategorinë e ekzoplaneteve. Në një botë të ngjashme me Neptunin, Kepler 51 d është më i lehtë. Madhësia shumë më e madhe e planetit të ri, e kombinuar me dendësinë e tij super të dritës, e bën atë të çuditshëm midis 5400 planetëve të tjerë të zbuluar deri më sot.
Zbulimi u bë nga një grup astronomësh nga universitete të ndryshme, duke përfshirë Institutin e Teknologjisë të Massachusetts (MIT) dhe Universitetin e Liege në Belgjikë, dhe u raportua në revistën Nature Astronomy.
Bashkautori i studimit në MIT, Julien de Wit, tha: “Zakonisht, planetët e mëdhenj janë mjaft të lehtë për t’u zbuluar, sepse ata janë zakonisht masivë dhe çojnë në një tërheqje të madhe në yllin e tyre. Por ajo që ishte e ndërlikuar për këtë planet ishte – edhe pse është i madh – masa dhe dendësia e tij janë aq të ulëta saqë në fakt ishte shumë e vështirë të zbulohej vetëm me teknikën e shpejtësisë radiale. Ishte një kthesë interesante.”
Për të kuptuar arsyen e lehtësisë së tij, shkencëtarët do të kryejnë më shumë teste.